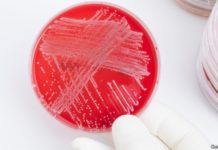
Vaccine researchers are preparing for Disease X

California to Send National Guard to Raid Pot Farms
Troops will be removed from President Donald Trump’s border fiasco to head north and destroy unlicensed marijuana grows.
By Jimi Devine
February 17, 2019
California Gov. Gavin Newsom...
Groundbreaking Study Shows Massive Reduction of Pesticides in Humans after One Week Organic Diet
The study, Organic Diet Intervention Significantly Reduces Urinary Pesticide Levels in U.S. Children and Adults, found significant reductions in pesticides that have been associated with increased risk of autism, cancers, autoimmune disorders, infertility, hormone disruption, and Alzheimer’s and Parkinson’s diseases
Vaccine researchers are preparing for Disease X
They hope to be able to create new vaccines in just four months
January 18, 2019
Last year the World Health Organisation published a plan to accelerate...
Flu shot lands man in hospital, unable to speak, walk, see or even BREATHE
A Las Vegas man lost his vision, became partially paralyzed and has been unable to breathe without assistance since getting a flu shot last month
Medical marijuana goes mainstream as seniors look to relieve chronic pain
It is no surprise then that the popularity of cannabis among seniors has been — and continues to be — on the rise
President Trump Signs Farm Bill that Legalizes Hemp
Hemp has very low THC content, the mind-altering chemical but is used to make textiles, foods, fabrics, cosmetics, agriculture products, plastics, and more
‘Horrifying’ marijuana sales in British Columbia a wake-up call for regulators
By Matt Lamers
October 26, 2018
British Columbia’s dismal cannabis sales in the opening hours of legalization should be seen by provincial and federal regulators as a...
Robert David Steele & Dustin Nemos with lots of ‘gold’ nuggets!
Robert David Steele was recommended for the Nobel Peace Prize in 2017
Mike Smyth: B.C.’s pot minister promises the best bud
B.C.'s online pot shop will offer 117 different strains and varieties of legal weed, cannabis minister reveals
Tough Questions to Ask White Rock Candidates, with Sheryl McCumsey
Why is White Rock Unwilling to Test Water for Pesticides?